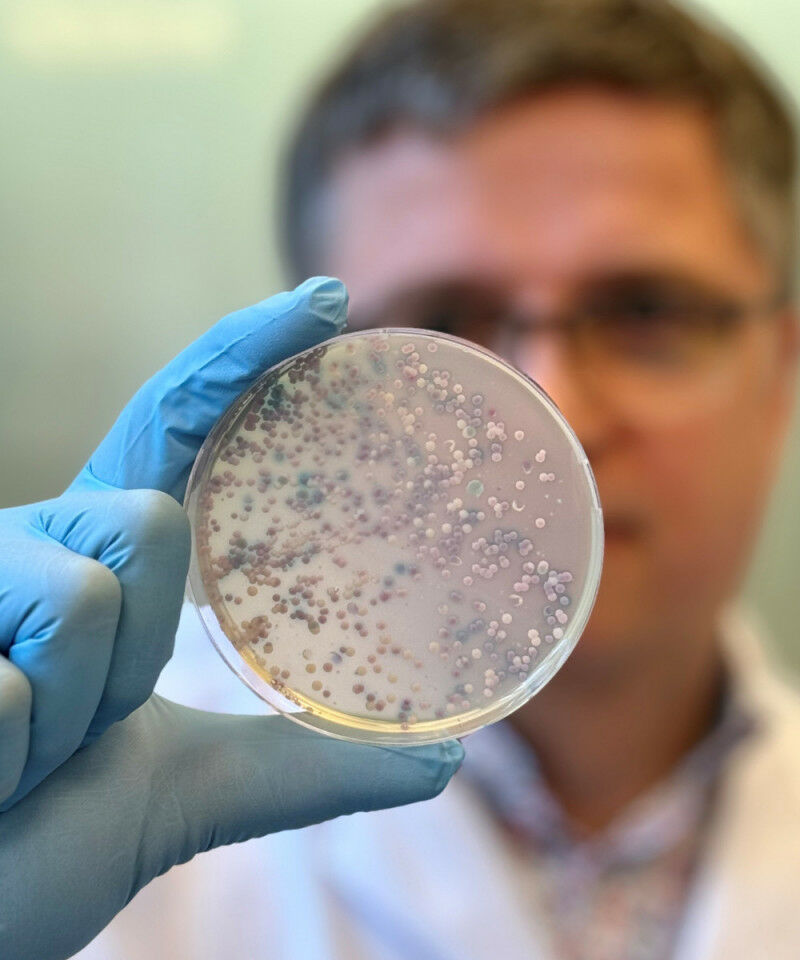
20240823 Ferry ChromoCandida1 - (C) Marjan Vermaas WI-KNAW

Diseases caused by Candida are among the most common fungal infections worldwide / The new guideline was developed over four years by a team of more than one hundred experts from 35 countries, including researchers from the University of Manchester
A team of international clinical experts led by Professor Dr Oliver A. Cornely and Dr Rosanne Sprute from University Hospital Cologne, including University of Manchester researchers, have published the new global guideline for the diagnosis and treatment of Candida infections.The guideline establishes new standards for managing fungal infections, which affect millions of people worldwide every year, and was recently published in Lancet Infectious Diseases.
The new guideline contains detailed recommendations on the prevention, diagnosis and treatment of various forms of candidiasis - from superficial infections to life-threatening invasive infections - for clinicians, including innovative diagnostic procedures and the latest therapeutic approaches.
Particular attention is paid to new challenges such as resistance to common antifungals and the increasing spread of Candida auris, a multiresistant pathogen
"With this guideline, we have taken an important step towards improving treatment for patients worldwide," said Professor Cornely, head of the global initiative. Co-lead Dr Sprute added: "Our aim was to pool the expertise of a global network to provide doctors and healthcare professionals with a practical and scientifically sound tool.
The document is the result of four years of intensive collaboration among more than one hundred experts from 35 countries. Supported by the expert associations ECMM (European Confederation of Medical Mycology), ISHAM (International Society for Human and Animal Mycology) and ASM (American Society for Microbiology).
It was a mammoth project to bring practically the world together to agree how to diagnose and manage the most common invasive fungal disease
Dr Cornely invited potential authors for the guideline based on speciality, geography, and gender. Six coordinators were appointed to ensure the structure of the guideline, assign topics, identify missing aspects and monitor progress.
The guideline has been endorsed worldwide by seventy six international expert associations as an important guide for practising physicians and meets the highest standards of quality and relevance to clinical care.
"Our compilation is unprecedented and provides a basis for improving the treatment and chances of survival of affected patients worldwide," said Cornely, underlining the significance of the work.
Dr Riina Rautemaa-Richardson, Senior Clinical Research Fellow at The University of Manchester said: ""It was a mammoth project to bring practically the world together to agree how to diagnose and manage the most common invasive fungal disease. For the first time, all continents are represented and all’aspects of Candida infections covered, including the very common superficial ones (thrush)."
"It was amazing to see how much more evidence there is to support the recommendations made compared to the previous European guideline 10 years ago. Although we had over 100 expert authors in the group it was easy to agree on the recommendations."


